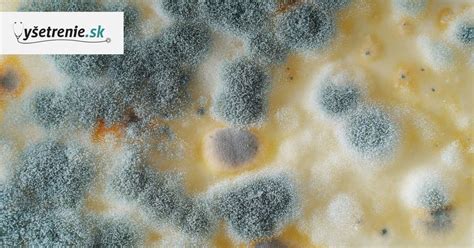
pleseň na jogurte

Až 42 percent potravinového odpadu v Európe produkujú domácnosti, často preto, že si nie sme istí, kedy je potravina ešte v poriadku a kedy už nie. Slováci podľa Európskej komisie vyprodukujú ročne 0,86 milióna ton potravinového odpadu, čo je dvakrát viac ako v susednom Česku. Dôvodom je, že sa riadime dátumami minimálnej trvanlivosti a spotreby, ktorým však často nerozumieme, a tak vyhadzujeme aj jedlo, ktoré by sme ešte mohli využiť. Tento článok sa zameriava na trvanlivosť jogurtu, faktory, ktoré ju ovplyvňujú, a ako rozpoznať, či je jogurt ešte vhodný na konzumáciu. Ako teda zistiť, či sa jogurt pokazil a ako predísť zbytočnému plytvaniu?
Dátum minimálnej trvanlivosti verzus dátum spotreby
Je dôležité rozlišovať medzi dátumom minimálnej trvanlivosti a dátumom spotreby. Dátum minimálnej trvanlivosti je len odporúčaním, dokedy by sa mal jogurt (alebo iná potravina) skonzumovať. Potravina by sa do tohto dátumu nemala pokaziť. Dátum spotreby je však údaj, po ktorého uplynutí by sme potravinu už radšej nemali konzumovať. Ak hovoríme o dátume minimálnej spotreby, tak ide len o odporúčanie, dokedy by sa jogurt mal zjesť. Je to dátum, do ktorého sa jogurt, alebo aj iné potraviny určite nepokazia.
Ako posúdiť, či je jogurt ešte dobrý
Aj keď prírodný jogurt vďaka obsahu dobrých baktérií vydrží až tri týždne, čo je často dlho po dátume spotreby, je dôležité vedieť rozpoznať znaky, že sa už nedá jesť. Jogurt skladovaný v chladničke vám vydrží jeden až tri týždne vďaka svojim dobrým baktériám. Keď tieto živé kultúry začnú postupne odumierať, kazí sa aj samotný jogurt. Avšak, dátum spotreby na obale nemusí byť vždy smerodajný. Tu je niekoľko spôsobov, ako posúdiť, či je jogurt ešte vhodný na konzumáciu:
Portál eatbydate.com odporúča pri zisťovaní, či je jogurt ešte jedlý, použiť svoje zmysly.
1. Vzhľad
Skontrolujte, či sa na povrchu jogurtu nevyskytuje pleseň. Ak spozorujete čo i len malú pleseň, treba vyhodiť celé balenie, pretože pleseň sa môže rýchlo šíriť. Aj jediný fliačik plesne znamená, že dobré baktérie v jogurte neprežili.
2. Konzistencia
Ak sa jogurt oddelil a má hrudkovitú konzistenciu, nemusí to hneď znamenať, že je pokazený. Môže sa stať, že sa iba oddelila srvátka, ktorú stačí zamiešať. Ak je však konzistencia výrazne zmenená a jogurt je slizký, radšej ho nejedzte. Ak sa na povrchu nachádza nadmerné množstvo vody, môže to byť znak, že jogurt nie je v poriadku. Menšie množstvo tekutiny, nazývanej srvátka, je však bežné a obsahuje živiny, ktoré sa odporúča vmiešať späť do jogurtu.
3. Vôňa
Ovoňajte jogurt. Ak má kyslú alebo nepríjemnú vôňu, pravdepodobne sa pokazil. Pokazený jogurt má silnú, kyslastú vôňu. Ak jogurt vonia normálne, pravdepodobne nie je pokazený.
4. Chuť
Ak jogurt vyzerá a vonia v poriadku, ochutnajte ho.
Vo všeobecnosti platí, že ak jogurt vyzerá dobre, nemá žiadne podozrivé zmeny farby, vône alebo chuti a bol správne skladovaný, môže byť bezpečné ho zjesť aj niekoľko dní po dátume spotreby. Takýto jogurt môžeš kľudne zjesť aj päť dní po tom, ako uplynul dátum spotreby. Častokrát dokonca aj neskôr. Ak bol kelímok správne skladovaný v chladničke bez prerušenia chladiaceho reťazca, môžete dátum bezpečne prekročiť aj o päť dní… A niekedy dokonca aj o pár týždňov či mesiac, najmä pri prirodzene fermentovaných bielych jogurtoch.

Ako predĺžiť trvanlivosť jogurtu
Dátum spotreby vieme ovplyvniť a to hlavne skladovaním potravín.
Skladovanie v chladničke
Jogurty by sa mali skladovať v chladničke, nie v polici alebo špajze. Vložte ich do chladničky hneď po príchode z obchodu.
Obmedzenie otvárania
Opätovné otváranie téglika skracuje trvanlivosť jogurtu. Ak zjete len polovicu jogurtu, uzavrite ho a vráťte do chladničky. Spotrebu jogurtu skracuje aj opätovné otváranie viečka. Ak zješ len polovicu jogurtu, zavrieš ho a následne ho vrátiš do chladničky, jeho doba spotreby sa skráti, pretože už bol otvorený.
Uzavretie
Jogurt vždy vráťte do chladničky s viečkom. Bez viečka sa do neho dostanú baktérie z chladničky a začne pohlcovať pachy z iných potravín. Ak jogurt vrátiš do chladničky bez viečka, dostanú sa do neho baktérie z chladničky a začne pohlcovať zápachy z iných jedál.
Ako udržať ovocie a zeleninu čo najdlhšie čerstvé? 22 tipov na skladovanie potravín v chladničke.
Čo robiť, ak ste zjedli jogurt po záruke
Ak ste zjedli jogurt po záruke a cítite sa dobre, pravdepodobne sa nič nestane. Hydratácia: Pite veľa tekutín, ako je voda alebo rehydratačný roztok, aby ste predišli dehydratácii. Lieky: Pri nekrvavej hnačke môžu voľnopredajné lieky, ako je loperamid alebo diosmektit, pomôcť znížiť frekvenciu stolice. Lekárska pomoc: Ak sú príznaky závažné alebo sa zhoršujú, vyhľadajte lekársku pomoc. Otrava jedlom zvyčajne trvá od niekoľkých hodín do niekoľkých dní, v závislosti od typu baktérie, vírusu alebo toxínu. Väčšina prípadov vymizne do 1 až 3 dní s príznakmi ako nevoľnosť, vracanie, hnačka a kŕče.
Reklamácia pokazeného jogurtu
Ak ste si kúpili jogurt, ktorý je pokazený ešte pred dátumom spotreby, máte právo ho reklamovať. Reklamáciu by ste mali podať čo najskôr po zistení vady. Nezabudnite si so sebou zobrať bloček od nákupu. Tovar podliehajúci rýchlej skaze sa musí podľa Občianskeho zákonníka reklamovať najneskôr v nasledujúci deň po kúpe. Predajca môže argumentovať, že zákazník tovar doma nesprávne skladoval, a teda ho sám pokazil.
Domáci jogurt
Domáci jogurt predstavuje nielen chutný a zdravý doplnok našej stravy, ale tiež skvelý spôsob, ako si užiť chute prispôsobené našim preferenciám. Okrem toho je jeho výroba jednoduchá a zabraňuje nám nákupu jogurtov s pridanými konzervačnými látkami.
Trvanlivosť domáceho jogurtu
Domáci jogurt, ak je správne vyrobený a uskladnený, má obvykle životnosť približne 7 až 10 dní v chladničke. Ak je domáci jogurt uložený správne v chladničke, obvykle vydrží 1-2 týždne. Je dôležité venovať pozornosť jeho vôni, chuti a vzhľadu.
Faktory ovplyvňujúce trvanlivosť domáceho jogurtu
Trvanlivosť domáceho jogurtu môže byť ovplyvnená niekoľkými faktormi:
- Kvalita ingrediencií: Mlieko a kultúry, ktoré použijete, ovplyvňujú konečný výsledok.
- Pridané suroviny: Ak do jogurtu zakomponujete ovocie, med alebo iné prísady, môže to ovplyvniť jeho životnosť.
- Teplota uskladnenia: Domáci jogurt by mal byť uskladnený v chladničke s teplotou 2-4 °C. Vyššie teploty môžu urýchliť skazenie.
- Hygiena: Pri výrobe jogurtu je kľúčové dodržiavať hygienické normy. Uistite sa, že všetky nádoby a nástroje, ktoré používate, sú dôkladne umyté a sterilné.
Ako vyrobiť domáci jogurt
Vyrobiť domáci jogurt vôbec nie je ťažké. Mnoho ľudí si myslí opak a preto sa do procesu výroby ani nepúšťa. Ak si raz pripravíte jogurt sami, tak iný už nebudete chcieť. Po ochutnaní vás očarí nielen jeho vynikajúca chuť, ale aj hustota a krémová konzistencia. Nehovoriac o tom, že doma vyrobený jogurt je pre zdravie veľmi prospešný. Niektorí z vás si určite myslia, že načo je dobré si doma vyrobiť jogurt, keď sa dá kúpiť. Áno, je pravda, že ponuka jogurtov je v obchodoch nielen široká, ale aj rozmanitá, a je jednoduchšie a zároveň aj pohodlnejšie si ho kúpiť. Avšak doma vyrobený jogurt prekoná aj tie najlepšie značky jogurtov.
Domáci jogurt si môžete vyrobiť dvoma spôsobmi. Klasickým spôsobom na sporáku v kombinácii s rúrou alebo pomocou jogurtovača. Výhodou prípravy domáceho jogurtu v jogurtovači je, že jogurt sa pripraví do praktických uzatvárateľných pohárov, ktoré sa jednoducho vložia do chladničky a po zjedení sa môžu opäť použiť. Ak však nechcete míňať peniaze na jogurtovač, domáci jogurt môžete pripraviť aj v hrnci na sporáku a potom ho dať na niekoľko hodín do rúry. Na výrobu domáceho jogurtu budete potrebovať iba dve suroviny - mlieko a jogurt. Výber týchto surovín je dôležitý, pretože ich kvalita zaistí, aby bol výsledný produkt nielen chutný, ale aj čistý.
Určite vás zaujíma, aké mlieko a jogurt použiť na výrobu domáceho jogurtu. Mlieko: použiť môžete v podstate akékoľvek mlieko. Pre kvalitný domáci jogurt sa odporúča použiť nepasterizované mlieko, ktoré kúpite v automate na mlieko. Biely jogurt so živou kultúrou: používa sa ako štartér a treba vybrať taký, ktorý má čisté zloženie a hlavne musí obsahovať živé kultúry. Tieto dobré baktérie zabezpečia proces fermentácie, ktorý je nevyhnutný pre výrobu jogurtu. Kúpiť ho môžete kdekoľvek, pokojne aj v obchode. Dôležité je zaoberať sa jeho zložením a vybrať taký, ktorý ho má čisté (dobrou voľbou sú jogurty s označením BIO).
Recept na domáci jogurt
Ako je vyššie spomenuté, na výrobu jogurtu budete potrebovať mlieko a biely jogurt. Základný pomer je jeden jogurt (zhruba 150 až 200 gramov) na 1 liter mlieka. Okrem toho si pripravte hrniec, naberačku, misku, sklenené poháre s uzatvárateľným viečkom, plech na pečenie. Mlieko zohrejte v hrnci na 82 až maximálne 88 °C. Mlieko nechajte vychladnúť na 41 až 45 °C. Ak nemáte k dispozícií teplomer, pomôžte si svojím prstom. Pridajte jogurtový štartér - dobré baktérie. Do misky si naberačkou odoberte časť mlieka (jednu šálku) a zamiešajte jeden biely jogurt. Zmes naplňte do pohárov. Poháre dajte do vyhriatej rúry na 50 °C zhruba na 7 až 9 hodín. Dobre uzavreté poháre dajte na plech a vložte do rúry vyhriatej na 50 °C a rúru vypnite. Jogurt nechajte vychladnúť a dajte do chladničky.
Vzniknutý jogurt je potrebné nechať vychladnúť pri izbovej teplote a následne ho odložiť do chladničky. Keď sa ochladí, bude hustejší. Doma vyrobený jogurt sa môže líšiť v závislosti od viacerých faktorov - od mlieka a jogurtu, ktoré použijete, od teploty mlieka a času prípravy, od nádoby, v ktorej sa pripravuje a podobne. Skúšaním a vylepšovaním viete časom vyrobiť domáci jogurt podľa vašich predstáv. Hustotu jogurtu ovplyvňuje typ použitého mlieka. Chuť jogurtu môžete ovplyvniť, ak ho ponecháte odstáť dlhší čas. Jogurt môžete nechať pri izbovej teplote až 48 hodín. Čím dlhšie odstane, tým je chuť kyslejšia a konzistencia hustejšia.
Tipy na predĺženie trvanlivosti domáceho jogurtu
- Udržujte chladničku v čistote: Pravidelne sledujte teplotu v chladničke a zabezpečte, že je dostatočne chladná.
- Zmrazte jogurt: Ak máte prebytok jogurtu, môžete ho zamraziť. V mrazničke udržíte kvalitu 1-2 mesiace. Po rozmrazení môže dôjsť k zmene textúry, avšak chuť by mala ostať nezmenená.
- Investujte do prvého štartéra - bieleho jogurtu so živou kultúrou.
- Jogurt pridajte do mlieka v správny čas.
- Teplomer je vynikajúcou pomôckou. Je pravda, že na prípravu jogurtu nie je potrebné používať teplomer, pretože teplotu zohriateho a schladeného mlieka stačí iba odhadnúť.
- V rúre nehýbte nádobami s jogurtom.
- Jogurt ochuťte až pred konzumovaním.
- Pre hustejšiu konzistenciu jogurt treba precediť. Ak dáte domáci jogurt do sitka s gázou, oddelí sa srvátka.
Je dôležité si všímať príznaky zhoršenia kvality jogurtu a v prípade pochybností ho radšej zlikvidujte.
